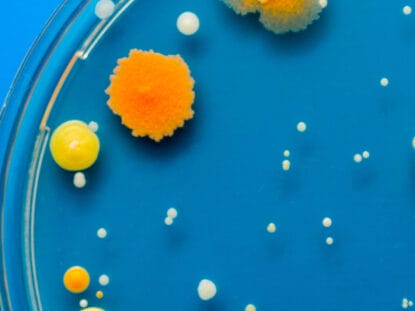
Proba, celule, stem, contaminata,

SVAP2030 este cea mai noua solutie ERP romaneasca
Soluție ERP românească – alegerea inteligentă pentru companiile din România și Europa De ce ai nevoie de o soluție ERP românească? Într-o economie aflată în continuă schimbare, companiile din România ...
Noua functionalitate SVAP2030: reconciliere automata ANAF
Nouă funcționalitate SVAP2030: reconciliere automată ANAF.
Generatia „six pack” sau generatia sanatoasa?
DIGIPEDIA explica stiinta miscarii la tineri - sedentarism sau obsesia pentru corpul perfect?
Impactul tehnologiei asupra copiilor
Tehnologia este un instrument valoros, dar trebuie inteleasa in raport cu dezvoltarea naturala a copilului.
ZEMCELPRO: stocare pe viata celule stem, validata!
Află cum Zemcelpro confirmă științific că celulele stem recoltate la naștere rămân valoroase zeci de ani.
AISIV: O VIATA MAI BUNA PRIN ROBOTII VORBITORI DE LA SIVECO
Descoperă cum AISIV optimizează procesele în organizația ta, redus costurile și îmbunătățește interacțiunea cu utilizatorii.
FARA COZI LA GHISEE PRIN RPA DE LA SIMAVI
Află cum RPA reduce hârtiile și drumurile inutile în lucrul cu instituțiile publice din România.
IWA: Asociatia Internationala a Femeilor
Cine sunt femeile din spatele Asociatiei Internationala a Femeilor din Bucuresti (IWA)?
Ingrosare penis - impresionant, rapid, fara durere.
Ingroasa-ti penisul intr-un mod eficient medical si total confidential. Fara durere!
Sanatatea companiilor se tine cu ERP SVAP2025
Sanatatea unei companii e legata de infrastructura. Beneficiile noului ERP SVAP2025 sunt vizibile imediat în economia unei companii!
CVDLINK si ingrijirea cardiovasculara
CVDLINK, un proiect finanțat de UE, ce combină medicina, cercetarea și AI în îngrijirea cardiovasculară prin soluții bazate pe date.
Pisicile nimanui sunt, de fapt, ale noastre!
Știi despre adăposturile pentru pisicile străzii oferite de către Consiliului Județean Ilfov, prin Direcția pentru Protecția Animalelor?
Cum am ajuns pe varful lui Imja Tse (Island Peak)
Doctor MiT a ajuns pe varful lui Island Peak (Imja Tse) in toamna lui 2024! Afla cum a decurs aventura si cati din echipa au reusit.
UTILIZAREA CELULELOR STEM: POT FI FOLOSITE LA ADULT?
Merita sa pastrezi toata viata celulele stem recoltate la nastere? Acest articol iti ofera raspunsul final.
Stil de viata sanatos - Anca Nicoiu-Suteu
Afla ce obiectiv are caietul de lucru pentru un stil de viata sanatos de la Anca Nicoiu-Suteu.
Ecografia cu Inteligenta Artificiala - VINNO cu A.I.
Ecografia AI - cu Inteligenta Artificiala - facuta cu ecograful VINNO maximizeaza pacientilor sansele la o viata perfecta.
Care sunt produsele moderne pentru menstruatie?
Femi.Eko ofera femeilor produse menstruale moderne ce le permit sa se simta mai bine, sa faca mai multe si care sunt eficiente economic si prietenoase cu mediul.
Istoria ADHD-ului în România
Până la recunoașterea recentă a prevalenței ADHD la adulți în România, viziunea asupra condiției a evoluat, însă tratamentul este limitat.
Sangele ombilical salveaza un copil afectat de stop cardiac
Afla despre copilul salvat cu sangele ombilical dupa un stop cardiac.
Autism și ADHD - similarități, simptome, tratament și implicații
Influenteaza alimentatia aparitia sau gravitatea simptomelor din ADHD?
Implantul cerebral reda mersul unui barbat paralizat
Iata cum un barbat paralizat poate merge din nou cu ajutorul implanturilor de creier si coloana vertebrala.
Despre mitul alimentatiei si simptomele de ADHD
Influenteaza alimentatia aparitia sau gravitatea simptomelor din ADHD?
Dyson Dust Study 2023
Iata rezultatele ce reies din studiul Dyson Dust Study, in premiera pentru Romania.
Tipuri de celule stem utilizate in mod curent
Iata tipurile de celule stem utilizate frecvent in transplanturi la nivel international.
TRATAMENT INCONTINENTA URINARA
Tratamentul artrozei cu Rigenera este singura terapie celulara specifica cu celule progenitorii din Romania. O singura interventie, cu rezultate de la 24-48 de ore!
Avea Iulia Marin ADHD? O analiza pe text si literatura medicala
Cum ar fi schimbat ADHD-ul situatia Iuliei? Investigam posibila comorbiditate si importanta diagnosticului diferential.
Asociatia NIA: sprijina adolescentii cu autism
Asociația NIA are misiunea de a ajuta adolescentii si adultii cu autism si isi doreste sa faca o schimbare semnificativa in comunitatea noastra.
2 Aprilie - Ziua internationala a autismului
Asociatia NIA are misiunea de a ajuta adolescentii si adultii cu autism si isi doreste sa faca o schimbare semnificativa in comunitatea noastra.
Lisdexamfetamina, promedicament rezistent la abuz pentru ADHD
Lisdexamfetamina este un promedicament pentru ADHD cu eliberare lenta si un risc scazut de abuz.
POVESTILE COPIILOR PENTRU PARINTI
Ce te faci cand nu stii daca copilul tau sufera de autism sau nu? Cum afli adevarul?
Top mituri si preconceptii despre ADHD
Despre ADHD pe larg - afla orice ai vrut sa stii vreodata despre tulburarea de deficit de atentie si hiperactivitate.
Asociatia NIA sustine persoanele cu autism
Asociata NIA se dedica in sustinerea persoanelor neurodivergente aflate in ingrijire.
Celule stem contaminate bacterian: mai pot fi folosite?
Celulele stem contaminate cu bacterii pot fi folosite in transplant? Afla raspunsul acum.
Infectiile urinare: cauze, diagnostic si tratament
Afla cum poti scapa de infectiile urinare recurente de la dr. Iosif Niculescu.
Neurologia pediatrica
Cand este cazul sa vizitezi neurologul pediatru si de ce este important?
BEME BEATS ACNE WITH THE HELP OF PROBIOTICS!
BeMe represents a new solution for acne treatment with the help of the probiotics.
Enterocolita la copii
Afla cum apare enterocolita la copii, cum se depisteaza si cum se trateaza, de la dr. Ionela Gheorghe.
TRATAMENT MODERN IN ARTROZA: RIGENERA!
Intr-o singura interventie ce dureaza doar o ora, terapia cu celule progenitoare opreste procesul degenerativ si stimuleaza refacerea tesutului cartilaginos.
Ecografia abdominala la copii
Ce semnifica examinarea ecografica la copii? Afla toate informatiile de la medicul specialist Adriana Amarandei.
Despre hormonul AMH si fertilitate
Afla despre hormonul AMH, marker-ul preferat al evaluarii potentialului fertil feminin de la dr. Andreea Veliscu.
Scoala poate fi "sanatoasa" pentru copiii nostri
Scoli Sanatoase - importanta sanatatii climatului interior in scoli.
Despre incontinenta urinara
Cum apare incontinenta urinara, cum o depistam si cum o tratam, aflam de la doctorul Iosif Niculescu.
Asigurare pentru autism STEMCARE | Tratament cu celule stem decontat
STEMCare Autism este singura asigurare pentru tratamentul autismului cu celule stem recoltate la nastere oferita prin Stem Sure.
Asigurare autism | Transplant cu celule stem decontat
Afla despre prima asigurare din Romania care acopera cheltuielile pentru tratamentul autismului lansata de Eurolife FFH & Stem Sure.
DA, EXISTA SUZETA PERFECTA!
Da, suzeta perfecta exista si ea bifeaza cateva caracteristici importante pentru sanatatea copilului!
Ziua Nationala a Transplantului - 2022
Pe 15 aprilie 2022 am sarbatorit Ziua Nationala a Transplantului. Iata cum a fost!
BOMBA ATOMICA SI IODUL: CE, CAT, CUM?
Bomba atomica ori explozie nucleara si tableta de iod; cand si cat sunt intrebarile la care Doctor MiT ofera cel mai clar raspuns!
Menopauza - semne, efecte si metode de gestionare
Afla cele mai importante informatii despre menopauza de la medicul ginecolog Iosif Niculescu
Am atins vârful prostiei?
Singurul leac pentru epidemia de idioțenie este să ne recunoaștem ignoranța.
AVORTUL SPONTAN. DE CE?
Iata motivele pentru care se poate declansa avortul spontan. Sunt unele pe care le poti controla chiar si in timpul sarcinii!
Noua tulpina Omicron - cat de periculoasa este?
Informatii in premiera despre omicron, noua tulpina de coronavirus. Cat de periculoasa este aceasta varianta?
Antigravitatia SPAD trateaza problemele de spate!
SPAD, solutia antigravitationala ce poate rezolva durerile de coloana, se gaseste la Bucuresti!
BeMe invinge acneea cu ajutorul probioticelor!
BeMe invinge acneea cu ajutorul probioticelor! Afla despre tratamentul anti acnee cu L. bulgaricus sub forma de gel, crema si corector.
DESPRE TROMBOFILIE PE INTELESUL TUTUROR
Totul despre trombofilie: trombofilia este o patologie periculoasa, mai ales in sarcina, si care poate ramane asimptomatica toata viata.
OBEZITATEA INFANTILA: DE CE SI CE SE POATE FACE?
Obezitatea infantila are cauze dar si solutii. Iata cum apare un copil supraponderal ori obez si cum se gestioneaza aceasta situatie!
RUPTURA DE LIGAMENT INCRUCISAT ANTERIOR (3)
Ruptura de ligament incrucisat anterior poate avea cateva rezolvari dupa cum ne spune dr. Mihai Rascu, fondator Ortokinetic. (Part. 3)
Calea sănătoasă către urmăritori pe Instagram
Calea sănătoasă către urmăritori pe Instagram: cumpărarea de urmăritori de înaltă calitate.
STUDIU STIINTIFIC: PANDEMIA, NASTERILE SI CELULELE STEM
Un studiu pe 10 ani ce investigheaza nasterea naturala versus cezariana, recoltarea si transplantul cu celule stem si impactul COVID-19.
TRATAMENT ARTROZA RIGENERA
Tratamentul artrozei cu Rigenera este singura terapie celulara specifica cu celule progenitorii din Romania. O singura interventie, cu rezultate de la 24-48 de ore!
BIOPTRON: INDICATIILE IN DERMATOLOGIE
Aplicatiile in dermatologie ale terapiei cu lumina Bioptron, pentru rezolvarea acneei, cicatricilor, antiaging si anti-imbatranire.
Tratament alopecie cu celule progenitoare Rigenera
Singurul tratament din Romania cu celule progenitorii prin microgrefare autolog-omologa pentru alopecie ce duce la recuperarea a pana la 30% din firele de par in 70% dintre cazuri!
Spray anti insecte natural pentru copii non-toxic
Solutia naturala 100%, eficienta impotriva tantarilor si capuselor, prietenoasa cu mediul si cu pielea copiilor inca de la varsta de 3 luni.
ACNEEA POATE FI INVINSA DE UN NOU LACTOBACIL
O bacterie speciala, Lactobacillus bulgaricus, lupta cu succes impotriva acneei! Aceasta se gaseste in formula completa de tratament BeMe.
Protejaza-ti nasul de rinitele alergice si Covid-19
Ai posibilitatea de a opri atat virusurile, ca SARS-CoV-2, cat si alergiile, direct la poarta de intrare, cu ajutorul spray-ului nazal Taffix!
Primul mare ars tratat cu microgrefe RIGENERA
In 2019 a fost tratat primul pacient ars din Romania cu un transplant autolog si omolog de microgrefe Rigenera. Iata rezultatele!
CAZURI DE TRATAMENT CU CELULE STEM TINERE
Celulele stem stem sunt folosite atat in tratarea bolilor de sange cat si a celor neuronale. Afla mai multe despre aceste cazuri!
AMBULANTA NEAGRA SI MITUL DESPRE ACEASTA
Am lansat o serie de 3 episoade Doctor MIT, sprijinite de catre Agentia Nationala de Transplant din Romania, despre Ambulanta Neagra.
RUPTURA DE LIGAMENT INCRUCISAT ANTERIOR (2)
Ruptura de ligament incrucisat anterior poate avea cateva rezolvari dupa cum ne spune dr. Mihai Rascu, fondator Ortokinetic. (Part. 2)
RUPTURA DE LIGAMENT INCRUCISAT ANTERIOR (1)
Ruptura de ligament incrucisat anterior poate avea cateva rezolvari dupa cum ne spune dr. Mihai Rascu, fondator Ortokinetic. (Part. 1)
IVERMECTINA: DA sau NU in COVID-19?
Toma Patrascu ne impartaseste gandurile sale despre ivermectina. Iata cum ar trebui sa te uiti la ea ca sa nu te pacalesti!
Romania contribuie la incalzirea globala
Dioxidul de carbon, gazele refrigerante cu efect de sera ori metanul sunt unii dintre cei mai seriosi agenti ce contribuie la incalzirea planetei
Copiii in Declaratia Universala a Drepturilor Omului
Cateva zeci de ani dupa adoptarea Declaratiei Drepturilor Omului apare Conventia Drepturilor Copilului. De ce atat de tarziu? Ce spune ea?
Parodontoza - cauze si metode de preventie
Parodontoza: de ce apare? Se”ia”? Ce poti face ca sa “n-o faci”? Fiecare intrebare are un raspuns in acest articol dedicat bolii parodontale.
TOP 5 MITURI POPULARE DESPRE CANCER
Te intrebi care este adevarul de spre cancer? Daca industria farma ascunde tratamentul sau daca simpla renuntare la zahar chiar il vindeca?
La ora 6, dupa razboi - pandemi de COVID-19
O plimbare erudita cu prof. Mironov, de la mimivirus la Be si He, ca, la final, sa intelegem legatura dintre SARS-CoV-2 si ora 6 dupa razboi.
ADEVARUL DESPRE IBUPROFEN IN TRATAREA COVID 19
Pana la urma care este adevarul despre utilizarea ibuprofenului in COVID-19? Iata aici concluzia finala, asa dupa cum o prezinta Doctor MIT!
Mituri si realitati despre cancerul pulmonar
Credintele despre cancerul pulmonar pot face mai mult rau decat bine. Afla adevarul din spatele celor mai comune 5 mituri despre aceasta boala!
COMPARATIE INTRE 3 VACCINURI ANTI-CORONAVIRUS
O comparatie concisa intre primele 3 vaccinuri anti-coronavirus: ce eficienta are fiecare, ce reactii adverse si cate unitati pot fi produse.
SPERMOGRAMA – analize in infertilitatea masculina (2)
In aceasta serie gasesti toate tipurile de analize efectuate pentru infertilitatea masculina alaturi de explicatiile tuturor diagnosticelor!
VACCINURILE ANTI-CORONAVIRUS - COMPARATIE
O comparatie usor de inteles intre vaccinurile anti coronavirus ce urmeaza sa fie aprobate pentru vaccinare + avantaje & dezavantaje.
CAT TINE IMUNITATEA LA CORONAVIRUS?
“Daca nu ai anticorpi, nu ai imunitate”. “Si daca ai avea imunitate, oricum tine prea putin”.
Care este adevarul?
Colagenul - element cheie pentru durerile articulare!
Odata cu inaintarea in varsta artroza devine a doua cauza de invaliditate la cei de peste 50 de ani. Afla cat de usor poti evita aceasta!
SPERMOGRAMA - analize in infertilitatea masculina (1)
Citeste pentru a afla ce analize se fac in infertilitatea masculina si ce semnifica fiecare rezultat pe care il indica acestea!
Infertilitatea masculina
Infertilitatea poate avea si cauze obiective, asa ca, a cauta “vinovatul” nu este ceva incorect pentru ca, astfel, poti indrepta situatia!
Infertilitatea o problema a multor cupluri
Infertilitatea poate avea si cauze obiective, situatie in care, a cauta “vinovatul” nu este ceva incorect pentru ca, astfel, poti indrepta situatia. Alteori, nimeni nu e “de vina”. Afla diferentele si cum se gestioneaza fiecare situatie!
Suferi de constipatie? Iata solutia naturala!
Suferi de constipatie? Iata solutia naturala oferita de Doctor MIT. Ciocolax este laxativul natural care combate constipatia.
Iata legatura dintre vaccinare si infectia cu HPV!
La fiecare 2 minute o femeie moare din cauza cancerului de col uterin. Previne! Trateaza! Ai grija de tine!
Operatia “prin gaura cheii” (histerectomia laparoscopica)
Laparoscopia reprezinta procedura prin care structurile intra-abdominale pot fi vizualizate cu ajutorul unui telescop subtire dotat cu o sursa de lumina introdus in abdomen printr-o incizie minima (1 cm), sub anestezie.
Poti ghici sexul copilului dupa forma burtii?
Ai deja un baietel si vrei sa ii aduci pe lume o surioara? Sau ai deja trei fete si crezi ca e momentul sa sa ai si un jucator de fotbal in familie. Ce poti face pentru a determina sexul viitorului copil?
RINITA ALERGICA: tot ce trebuie sa stii!
Stiai ca rinita alergica poate afecta IQ-ul copilului tau?
Afla in acest articol de ce se intampla aceasta si, mai ales, cum poti remedia aceasta alergie!
A venit momentul sa renunti la obezitate!
A venit momentul sa renunti la obezitate! Acum ceva vreme cineva s-a infiltrat in viata ta. Cu timpul, incet dar sigur ai aflat ca se numeste Obezitate. De cand ai ...
Cum sa scapi de simptomele provocate de rinita alergica?
Tu stii cum sa scapi de simptomele suparatoare ale rinitei?
Ibuprofen poate fi utilizat in COVID-19!
Autoritatile confirma ca NU EXISTA dovezi stiintifice despre legaturi intre administrarea ibuprofenului si agravarea evolutiei COVID-19!
SCREENING-UL GENETIC parental - o necesitate PART. 1
Suntem in mare parte responsabili noi, parintii, care asiguram bagajul genetic – optim – viitorului omulet.
SCREENING-UL GENETIC parental - o necesitate PART. 2
Doctorul Nicolae Poiana, conferentiar universitar, este Medic Primar Obstetrica-Ginecologie si Chirurgie Oncologica ce detine supraspecializari in medicina reproductiva asistata medical (fertilizare in vitro).
SCREENING-UL GENETIC parental - o necesitate PART. 3
Exist un test, singurul de altfel, care iti spoate spune din timp, daca fatul prezinta anomalii genetice. Acest test diagnostic, accesibil inca din primul trimestru, se numeste VILOCENTEZA.
MANUSI DE PROTECTIE
Mana este principalul responsabil pentru preluarea virionilor, bacteriilor ori parazitilor si expunerea acestora la nivelul mucoaselor, poarta de intrare principala pentru majoritatea virusurilor precum coronavirusul.
Ce e vital sa stie o gravida in epidemia de COVID-19?
Ce este vital sa stie o gravida in epidemia de coronavirus?
TRATAREA VIRUSULUI COVID-19 CU CELULE STEM
Tratarea virusului Covid-19 cu celule stem
Solutii sanatoase la sedinte, meetinguri sau conferinte
Iata solutiile alternative sanatoase pentru sedinte, meetinguri sau conferinte
Tratamentul autismului cu celule stem tinere - tehnologie
Autismul ocupa un loc central intre subiectele controversate ale societatii noastre de azi. Folosit ca principal argument pentru retragerea copiilor de la imunizarea cu vaccinuri anti rubeola-rujeola-oreion (ROR), autismul este ...
Tratament autism cu celule stem
In Romania avem un tratament pentru autism folosind celule stem hematopoietice recoltate la nastere. Iata toate detaliile aici!
Colagenul pentru frumusete si santate
Ai auzit despre el de la expertii din domeniul sanatatii. Ba mai mult, chiar si cea mai buna prietena ti-a vorbit despre el incantata.
Rigenera - primul tratament in Romania cu celule progenitoare
Afla totul despre cea mai inovatoare terapie celulara ce poate trata artroza, escarele, piciorul diabetic, arsurile si vitiligo!
Roumania's first stem cells transplant for autistic child
PREMIERE: THE FIRST STEM CELL TRANSPLANT WAS PERFORMED IN ROMANIA, TO TREAT AUTISM, WITH A SAMPLE RELEASED BY STEM SURE This medical premiere is the first transplant performed in Romania ...
Castigatoarea tombolei Doctor MIT
“O lume de explorat, un carucior de castigat!”. Campania noastra promotionala este gandita pentru a veni in sprijinul viitorilor parinti.
Tratament pentru diabet ce protejeaza inima
Un medicament inovator pentru tratamentul diabetului de tip 2 a fost introdus pe lista medicamentelor compensate 100% din România
Regulamentul Concursului “O lume de explorat, un carucior de castigat!”
Concursul “O lume de explorat, un carucior de castigat!” va avea loc in perioada 22 noiembrie – 21 ianuarie 2019.
Workshop Doctor MIT Family - 8 septembrie 2018
Workshop-urile Doctor MIT Family debuteaza in aceasta toamna, prima editie avand loc pe 8 septembrie, in cadrul Baby Boom.
Cel mai eficient sirop de tuse e aici!
În zilele noastre, producerea mierii de albine este un proces complex deoarece rezultatul trebuie să fie un aliment deosebit de plăcut si hrănitor.
Lupta eficient cu tusea!
Mărturiile istorice stau drept dovadă că mierea a fost folosită încă din cele mai vechi timpuri drept adjuvant în protejarea sănătății și a frumuseții, devenind un adevărat remediu naturist cu nenumărate calități.
Descopera in 5 minute daca ai OSTEOPOROZA!
Descopera daca ai ostoporoza cu un test de 5 minute.
Vindeca escara! Afla ce te poate ajuta!
Escara este cosmarul oricarui pacient imobilizat la pat si spaima fiecarui medic. Iata o solutie la aceasta problema oferita de Hartmann.
Antiinflamator complet natural!
Antiinflamator complet natural! Tripernol – suplimentul alimentar care combate eficient durerile prin efectul sau antiinflamator! Datorita formulei sale unice cu concentratie de extract uleios de scoica verde, nu din pulbere ...
Adevarul despre colesterol - HDL si LDL
Adevarul despre colesterol Alimentația dezechilibrată poate conduce la creșterea nivelului de colesterol din sânge. Un stil de viață sedentar și consumul de alimente bogate în grăsimi animale sau vegetale ne ...
Cancer de prostata - solutii
Cancer de prostata - solutii Ce trebuie sa stiu despre prostata? Prostata este o glanda ce se afla in spatele si sub vezica urinara. Prin prostata trece uretra, tubul prin ...
Hai la Baby Sanador!
In cadrul evenimentului Zilele Baby la Sanador, la dorința viitorilor părinți se pot organiza vizite în maternitate.
Gaseste aici, solutia care te scapa de depresie!
Gaseste aici, solutia care te scapa de depresie!
Artroza ar putea fi vindecata? Afla in acest articol!
Este aproape incredibil dar, dupa varsta de 50 de ani, artroza afecteaza 8 din 10 oameni. Din nefericire faptul ca aparitia acestei boli este tratat ca ceva firesc la persoanele ce se apropie de varsta a doua si a treia impiedica adesea pacientii sa caute solutii.
Prebiotice sau Probiotice?
PRE sau PRO-biotice?
De ce unele formule prezinta doar unul dintre ele si de ce, altele, decid sa le combine?
Un gram de sanatate...
De cate ori ai mers in supermarket, hypermarket sau in piata si nu ai gasit produsele de care aveai nevoie pentru tine si copilul tau?
Ce stii despre resveratrol? Revidox aliatul tineretii celulare.
Revidox - bogat in resveratrol este aliatul tineretii celulare. Descopera cele mai importante informatii!
Celule stem, banca & garantii?
Stem SURE te asigura că, în orice situaţie, probele recoltate în România şi stocate în banca sa, se află în siguranţă!
Cat iti gradinaresti sanatatea?
Cat iti gradinaresti sanatatea? Sanatatea noastra este adesea comparata cu o gradina infloritoare. Asadar, noi suntem gradinarii care o ingrijesc pe tot parcursul vietii, dedicand timp si resurse pentru a ne asigura ...
Nastere & perineu puternic?!?
Tot mai raspandita este credinta ca perineul se relaxeaza sau, mai popular spus, "se slabeste" daca nasti pe cale naturala; din pacate acesta este unul dintre motivele ce determina femeile sa opteze pentru nasterea prin operatia cezariana.
Pentru ca este un subiect foarte serios, care intereseaza direct gravida cat si partenerul ei prin prisma vietii sexuale, am rugat-o pe Vania Limban, moasa, sa ne spuna ce crede despre acest mit.